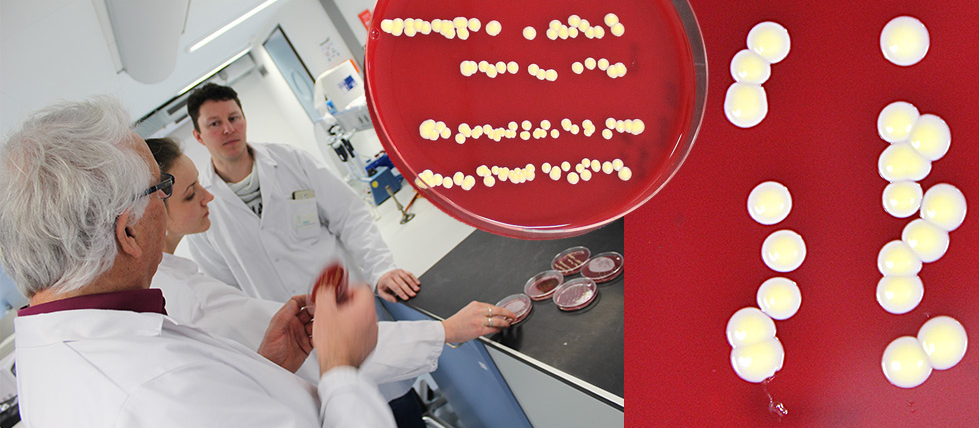

[Scientists] Preregistratie & Van Start!
Vandaag start Mastivax hun pilotexperiment. Mastivax ontwikkelt alternatieven voor antibiotica in de melkveehouderij die gebruik maken van het natuurlijke afweersysteem van de koe. Afgelopen 1,5 jaar heb ik met Mastivax samengewerkt en een bedrijf getroffen met een gezonde dosis wetenschappelijke nieuwsgierigheid naar de variatie in mastitiskoeien, de verschillen tussen bacteriële infecties in meetresultaten en de zuiverheid van experimenteel ontwerp om onder die omstandigheden hun behandelingen te testen. Succes in deze pilot zou een grote stap kunnen zijn voor de bestrijding van antibioticaresistentie wereldwijd. Maar hoe dan ook gaat dit experiment veel interessante inzichten opleveren omdat Mastivax zoveel mogelijk onvertekende resultaten probeert te verzamelen. Dat is dankzij de strikte proefopzet, poweranalyse en het nauwgezette analyseplan dat Mastivax twee weken geleden heeft gepreregistreerd op preclinicaltrials.eu (onder embargo). Daarmee is Mastivax het eerste bedrijf in het register van deze vooruitstrevende Nederlandse website en een voorloper in de beweging voor betrouwbaarder en minder verspillend proefdieronderzoek (Macleod (2011), Jansen of Lorkeers et al (2014)).
https://www.preclinicaltrials.eu/
Mon, 22 October
